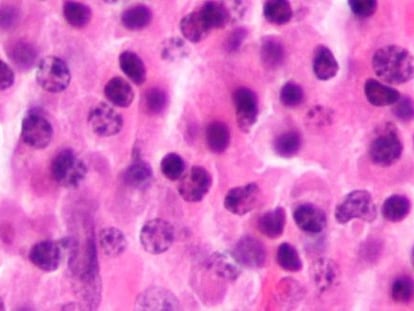

Una inmunoterapia contra el cáncer 100% española
El medicamento nació en el CNIO, se desarrolló en Valencia y se ensaya en Madrid y Pamplona

El medicamento nació en el CNIO, se desarrolló en Valencia y se ensaya en Madrid y Pamplona

Los 24.000 casos nuevos detectados en 2016 incrementan la demanda de apoyo social y psicológico

El envejecimiento hizo que en 2015 se superaran los diagnósticos previstos para 2020

El padre de la bioinformática explica cómo la computación puede ayudar a comprender la complejidad de cada tumor y buscar tratamientos especializados

La oncóloga de Vall d'Hebron estudia los mecanismos de resistencia de los tumores a los fármacos

La medicina personalizada y la inmunoterapia, ralentizadas por la falta de biomarcadores que permitan tratamientos específicos para cada tipo de tumor

Esta enfermedad es el principal tumor en jóvenes y la tercera causa de muerte por cáncer en niños

La bióloga desarrolla métodos computacionales para identificar alteraciones genéticas vinculadas a la aparición de los tumores

Unas 138.600 personas aguardan una prueba diagnóstica y otras 552.100 por una visita al especialista

Salud registra en la última década una disminución del 75% en las muertes a 30 días tras una cirugía de cáncer de esófago

Salut registra en l'última dècada una disminució del 75% de les morts 30 dies després d'una cirurgia de càncer d'esòfag

Investigadores plantean imprimir copias de neoplasias para probar el tratamiento en el dispositivo de plástico antes que en el paciente

El oncólogo afirma que médicos, laboratorios, Administración y pacientes tienen que actuar conjuntamente

'Day of Life' es un evento organizado por la Asociación Española de Fisioterapia Oncológica por la investigación en secuelas de tratamientos contra el cáncer

El 18 de junio la Asociación Española de Fisioterapia Oncológica celebra un evento solidario en Las Rozas para conmemorar "lo que nos hace disfrutar"

La moderna inmunoterapia se basa en desenmascarar las células tumorales

Los centros se someten a una evaluación de especialistas estadounidenses y sacan un 8 sobre 10

Un grupo de la Universidad de Maguncia (Alemania) prueba en ratones y en tres pacientes un nuevo sistema que permite al sistema inmune responder contra algunos tumores

Los especialistas afirman que hay 284 unidades más otras nueve pediátricas

Los oncólogos afirman que un tercio de los pacientes no reciben tratamiento por falta de instrumental

Un fármaco combate hasta el 60% de los carcinomas basocelulares graves

Una nueva formulación se muestra más eficaz en los cánceres de mama de peor pronóstico

España es el tercer país de la UE con mayor porcentaje de muerte por esta enfermedad entre menores de 65 años, según datos de Eurostat en el Día Mundial contra el Cáncer

La sociedad médica de la especialidad calcula que faltan 77 unidades y 155 profesionales

La combinación de medicamentos y el inicio de estudios para lograr nuevos fármacos en los casos más graves son clave para intentar frenar actualmente los procesos cancerosos
El diagnóstico por imagen usa tecnologías de la información para ser más eficiente

El campus científico del Vall d’Hebron es el complejo sanitario que realiza más ensayos clínicos en el país, cerca de 900 cada año

La directora del Centro Nacional de Investigaciones Oncológicas cree que España está a la vanguardia de la investigación celular pero debe recuperar inversiones

Las bacterias intestinales pueden potenciar la eficacia de nuevos tratamientos oncológicos

L’investigador va ser qui va descriure per primera vegada una cèl·lula mare de l’intestí

El investigador fue quien describió por primera vez una célula madre del intestino
“En España se toma casi cuatro veces la cantidad de carne roja recomendada”, dice el principal autor español del trabajo sobre dieta y mortalidad El trabajo no sorprende a los expertos
"La inmunoterapia es una revolución que está evolucionando", afirma James Allison, uno de los pioneros de esta aproximación

Un estudio demuestra la eficacia de la biopsia líquida para identificar algunos tumores que no se detectan con la de tejidos

El centro, pionero en España, da atención integral a los menores enfermos y a sus familias

L'establiment inaugura un centre de dia pioner a Espanya per donar una atenció integral als menors malalts i a les seves famílies

Un estudi demostra l'eficàcia de la biòpsia líquida per identificar tumors indetectables amb la biòpsia de teixits

Una droga antitumoral experimental que se dirige con luz azul logra en laboratorio reducir los efectos tóxicos de la quimioterapia

El prestigiós metge i actual director del Vall d’Hebron Institut d'Oncologia (VHIO) regirà la institució internacional el 2018

El prestigioso médico y actual director del Vall d’Hebron Instituto de Oncología (VHIO) regirá la institución internacional en 2018